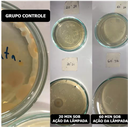

Notícias
Caucaia desenvolve sistema automático de desinfecção por meio de luz ultravioleta
PESQUISA
última modificação:
05/05/2022 16h04
O projeto foi financiado pela Pró-Reitoria de Pesquisa e Pós-Graduação e Inovação (PRPI/IFCE)